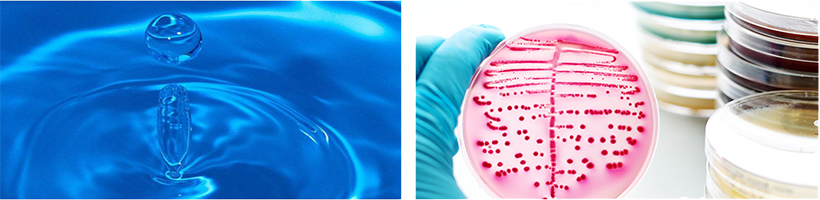
08

食品(pǐn)飲料行業解決方案
君浩環保作為一家17年行業經驗的工程(chéng)定製廠家,致力於工業純水係(xì)統一(yī)站(zhàn)式解決方案
成功應用在20個行(háng)業100+項工業用水的高效(xiào)率處(chù)理工程

麵(miàn)臨問題
 |
|
隨著全球(qiú)汙染的加劇和人們對健康的追(zhuī)求,對食品、飲料行業也提出(chū)了更加嚴(yán)格的要(yào)求。普通的市政自來水或地下深(shēn)井水已(yǐ)很難滿足人們的需求。現對眾多食品及所有飲料行業實施食品衛生(shēng)安全許可製度,規定所用工藝水(shuǐ)及成品水(shuǐ)均需要用淨水後的水,通常是純(chún)水。 |
純水水質要求解讀
在食(shí)品和飲料生產中(zhōng),為了除去原水(shuǐ)中含有大量的離子,微生物,細菌,沉澱等(děng)以保證生產的衛生、保存(cún)和正常發酵;因此需要對原水的處理是必(bì)須的。普通水的需求:純水電導率在10us/cm以下,軟化總(zǒng)硬度小於(以CaCO3計),30毫克/升。
在食(shí)品和飲料生產中(zhōng),為了除去原水(shuǐ)中含有大量的離子,微生物,細菌,沉澱等(děng)以保證生產的衛生、保存(cún)和正常發酵;因此需要對原水的處理是必(bì)須的。普通水的需求:純水電導率在10us/cm以下,軟化總(zǒng)硬度小於(以CaCO3計),30毫克/升。

君浩環保方案優勢
基於(yú)成熟的技術創新集成式純化水工藝,成功應用(yòng)在20個行業100+項(xiàng)工業用水的高效率處理工程
采用國內外一線知名品牌,以安全可靠的品質成功應用在工業純化水(shuǐ)處(chù)理工程現場
提供準確的(de)工藝方(fāng)案技術,總經濟成本分析報告(gào),含(係(xì)統裝機成本/係統藥劑成本/係統運行成本)等
君浩環保工(gōng)業信息化(huà)管理,可實現(xiàn)交付可視化
純化(huà)水(shuǐ)係統嚴格經過30餘道工(gōng)序匠心製造,君(jun1)浩環保工程模(mó)塊,均可采用現場組裝,可升級,可移動

![]() 集成工藝
集成工藝
![]() 核心部件應用
核心部件應用
![]() 經濟計劃書
經濟計劃書
![]() 信息化管理
信息化管理
![]() 模塊化製造
模塊化製造





